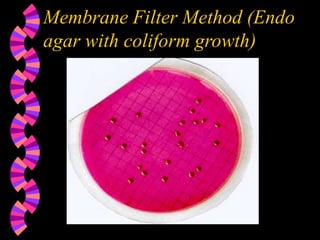
Membrane Filter Method (Endo
agar with coliform growth)

This document discusses microorganisms and coliform bacteria as indicators of water quality. It describes various pathogens that can be transmitted through contaminated water and issues with directly testing for all pathogens. Coliform bacteria are discussed as reliable indicators of fecal contamination in water that are easier to detect than pathogens. The document outlines approved methods for testing drinking water and surface water for total coliforms and E. coli, including membrane filtration, multiple tube fermentation, and presence-absence tests. Holding times and certification of laboratories to conduct these analyses are also summarized.


























![Coliform Sample Holding Times
drinking water - 30 hours
[40 CFR 141.21(f)]
surface/source water - 8 hours
[40 CFR 141.74 (a)(1)]](https://image.slidesharecdn.com/microorg32-240128155136-4f9f5d98/85/microooooooooooooooooooooooorg_3-2-ppt-27-320.jpg)




![Choosing a Laboratory for
Testing
laboratory must be certified by the State or
EPA to conduct analyses of compliance
drinking water and surface/source water
samples [40 CFR 141.28(a), 40 CFR
141.74(a)]](https://image.slidesharecdn.com/microorg32-240128155136-4f9f5d98/85/microooooooooooooooooooooooorg_3-2-ppt-32-320.jpg)



![Approved Drinking Water
Methods [40 CFR 141.21 (f)]
Membrane Filter Method - total coliforms, fecal
coliforms, E. coli
Multiple Tube Fermentation Method- total
coliforms, fecal coliforms, E. coli](https://image.slidesharecdn.com/microorg32-240128155136-4f9f5d98/85/microooooooooooooooooooooooorg_3-2-ppt-36-320.jpg)
![Approved Drinking Water
Methods [40 CFR 141.21 (f)]
Presence/Absence Method -total coliforms,
fecal coliforms, E. coli
Colilert Method - total coliforms, E. coli
Colisure Method - total coliforms, E. coli](https://image.slidesharecdn.com/microorg32-240128155136-4f9f5d98/85/microooooooooooooooooooooooorg_3-2-ppt-37-320.jpg)